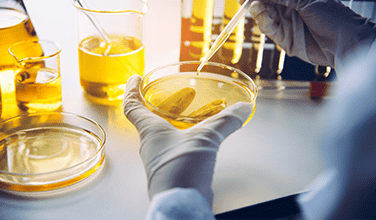

Our Client Success Stories
Innovation at Work - How We Solve Real-World Challenges
Explore real-world examples of how Sensemech empowers clients to achieve remarkable results.
01
Intelligent 3-Phase Motor Protection System
Solution: Sensemech designed a smart unit that monitors critical parameters like current, voltage, phase sequence and phase imbalance. It integrates with pressure switches via digital inputs and provides digital outputs to control connected devices for optimized process control. This system offers real-time error detection (high voltage/current) with automatic motor shutdown and provides error data on cloud using IoT modem. This enables remote monitoring and keeps users informed about motor status and potential issues.
Remote Oil Quality Monitoring with PCM
Solution: Sensemech's Power and Communication Module (PCM) addresses this. It provides:
• 24+ Hour Power: Sustained power for the oil particle counter sensor.
• Data Storage: Local memory for storing sensor readings for later access.
• Data Retrieval & Analysis: Android app retrieves data, processes it and generates printouts on a POS machine.
• Wireless Data Transmission: Data can be sent via email, SMS, Whats App or cloud storage.
• Wireless Readings (Bluetooth): Safe data collection from sensors on vehicles in hazardous areas.
The PCM's long-lasting battery and Bluetooth connectivity enable remote monitoring, eliminating the need for manual intervention and improving worker safety.
02
03
Reliable Emergency LED Signage
Challenge: Traditional signage lacked backup power, leaving areas vulnerable during outages.
Solution: Sensemech designed a unique LED signage solution with:
• AC/Battery Power: Seamless switching to a 3+ hour battery backup during outages.
• Battery Monitoring: Alerts for low or damaged batteries with LED indicators.
• Circuit Protection: Safeguards against short circuits and overheating.
• Compliance: CE/RoHS certified for safety and environmental responsibility.
This reliable signage provides uninterrupted illumination, ensuring safety and visibility even in emergencies. Sensemech delivers fully tested and branded units with ongoing technical support.
Versatile Water Meter for Efficient Management
Solution: Sensemech's water meter overcomes these limitations with:
• Wide Input Voltage Range: Compatible with various power sources for flexible installation.
• Rugged Power Supply: Reliable operation even in harsh environments.
• RS-485 Communication: Seamless integration into monitoring networks for centralized data collection.
• Monochrome OLED Display: Clear on-site data visualization for informed decision-making.
This versatile meter empowers efficient water management through its adaptability, user-friendly display and easy integration capabilities.
04
05
Tailoring Sensor Performance with Amplification Boards
Solution: Sensemech's sensor amplification boards address this by:
• Amplifying Signals: Boosting weak sensor outputs to usable levels.
• Post-Processing Data: Refining and conditioning sensor data for accurate readings.
This customization ensures reliable and valuable data acquisition from various sensors, leading to improved process efficiency and informed decision-making.
Smart Bin- Smarter Waste Management
Solution: Sensemech's Smart Bin uses weight sensors and fill-level indicators to transmit real-time data wirelessly.
Impact: Optimized routes, reduced overflows and improved efficiency save companies money and minimize environmental impact. Scalable for various environments, Sensemech's Smart Bin paves the way for a smarter waste management future.